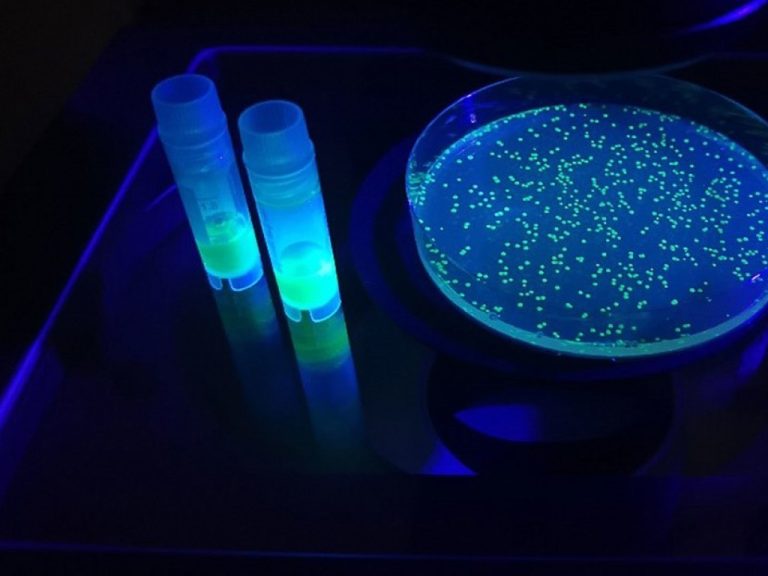
Un biosensor fluorescente rastreará inflamaciones desde dentro de los tejidos

Nueva York, 14 de enero de 2022 (Agencias).- Muere Adalia Rose Williams, una adolescente youtuber que narraba...
Mes: enero 2022
Mérida, Yucatán, 14 de enero de 2022 (Agencias).- El Ayuntamiento trabaja en múltiples cosas para elevar la...
Moscú, Rusia, 14 de enero de 2022 (Agencias).- Un equipo de científicos de la Universidad Médica de...
Mérida, Yucatán, 14 de enero de 2022 (Agencias).- Tras el anuncio del banco estadounidense Citigroupque cerrará sus operaciones...
-Con este esfuerzo por parte del Gobierno de Mauricio Vila Dosal se renovó la imagen y reacondicionaron...
-Como nunca, la población yucateca mostró unión y responsabilidad, para salir adelante ante las adversidades y cuidarnos...
Mérida, Yucatán, 11 de enero de 2022 (Boletín).- En reconocimiento a su trayectoria en labores humanistas y...
-La compañía establecerá centros de servicios en Tekax, Valladolid y Mérida, acercando las oportunidades laborales a jóvenes...
Ciudad de México, 10 de enero de 2022 (Agencias).- Titulares de las 31 entidades federativas del país...
Ciudad de México, 10 de enero de 2022 (Agencias).- Onésimo Cepeda, obispo emérito de Ecatepec, fue intubado...